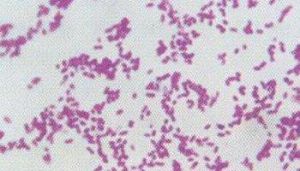
鮑曼不動桿菌

基本簡介
 不動桿菌
不動桿菌中文菌名:Chinese Name不動桿菌。
拉丁別名:Other Strain Name。
分離基物:Habitat。
用途:Usage The strain used for produces L(+) tartaric acid with medium GYA。
培養溫度:Temperature 30℃。
培養:基Media Number 197。
備註:一群不發酵糖類,氧化酶陰性,不能運動的革蘭陰性桿菌。
生物學特性革蘭陰性球桿菌,常見成對排列,可單個存在,有時形成絲狀和鏈狀,菌體大小為1.5~2.5UM,革蘭染色不易褪色,粘液性型菌株有莢膜,無芽孢,無鞭毛。專性需氧,營養要求一般,普通培養基上生長良好,最適生長溫度為35度,有些菌株可在42度生長。能在麥康凱瓊脂培養基上生長,但在SS瓊脂培養基上只有部分菌柱生長。
生化氧化酶陰性,動力陰性,硝酸鹽試驗陰性,為該菌的典型三陰。
流行病學
不動桿菌廣泛分布於外界環境中,主要在水體和土壤中,易在潮濕環境中生存,如浴盆、肥皂盒等處。該菌粘附力極強,易在各類醫用材料上粘附,而可能成為貯菌源。此外,本菌還存在於健康人皮膚(25%)、咽部(7%),也存在於結膜、唾液、胃腸道及陰道分泌物中。感染源可以是病人自身(內源性感染),亦可以是不動桿菌感染者或帶菌者,尤其是雙手帶菌的醫務人員。傳播途徑有接觸傳播和空氣傳播。在醫院里,污染的醫療器械及工作人員的手是重要的傳播媒介。易感者為老年患者、早產兒和新生兒,手術創傷、嚴重燒傷、氣管切開或插管、使用人工呼吸機、行靜脈導管和腹膜透析者,廣譜抗菌藥物或免疫抑制劑套用者等。在使用呼吸機者中,肺炎發生率約為3%~5%。
機理:條件致病菌。
臨床表現
鮑曼不動桿菌
鮑曼不動桿菌二、傷口及皮膚感染手術切口、燒傷及創傷的傷口,均易繼發不動桿菌皮膚感染,或與其他細菌一起造成混合感染。臨床特點與其他細菌所致感染並無明顯不同。多無發熱。偶可表現為蜂窩織炎。
三、泌尿生殖系統感染不動桿菌可引起腎盂腎炎、膀胱炎、尿道炎、陰道炎等,亦可呈無症狀菌尿症,但臨床上無法與其他細菌所致感染區別,其誘因多為留置導尿、膀胱造瘺等。
四、菌血症菌血症為不動桿菌感染中最嚴重的臨床類型,病死率達30%以上。多為繼發於其他部位感染或靜脈導管術後,少數原發於輸液、包括輸注抗生素、皮質類固醇、抗腫瘤藥物等之後。有發熱、全身中毒症狀、皮膚瘀點或瘀斑以及肝脾腫大等,重者有感染性休克。少數可與其他細菌形成複數菌菌血症。
五、腦膜炎多發於顱腦手術後。有發熱、頭痛、嘔吐、頸強直、凱爾尼格征陽性等化膿性腦膜炎表現。
實驗室:白細胞總數正常或增多,中性粒細胞數增加.經防污染採樣技術獲得的痰標本,診斷價值較大。痰塗片發現革蘭陰性球桿菌可成為診斷的重要線索。
治療
不動桿菌的耐藥率呈上升趨勢,有的上升較快(如環丙沙星),耐藥率一直保持在較高水平的有氨苄西林、頭孢唑啉及氯黴素等。耐藥率尚較低的有亞胺培南-西司他丁、頭孢他啶、頭孢哌酮-舒巴坦、氨苄西林-舒巴坦,哌拉西林-他唑巴坦及阿米卡星等。
在經驗用藥階段,往往首選頭孢哌酮-舒巴坦、亞胺培南-西司他丁,還可選用氨苄西林-舒巴坦、替卡西林-克拉維酸、阿米卡星、新一代氟喹諾酮類。對病情較重者,主張β-內醯胺類與氨基糖苷類(或氟喹諾酮類,或利福平)聯合套用。然後,則根據藥敏結果調整選用方案。
預後
影響本病預後的因素是基礎病的嚴重程度、引起感染的誘因能否消除、治療的早晚以及抗菌方案是否合理等。肺部感染與菌血症的預後較差。

